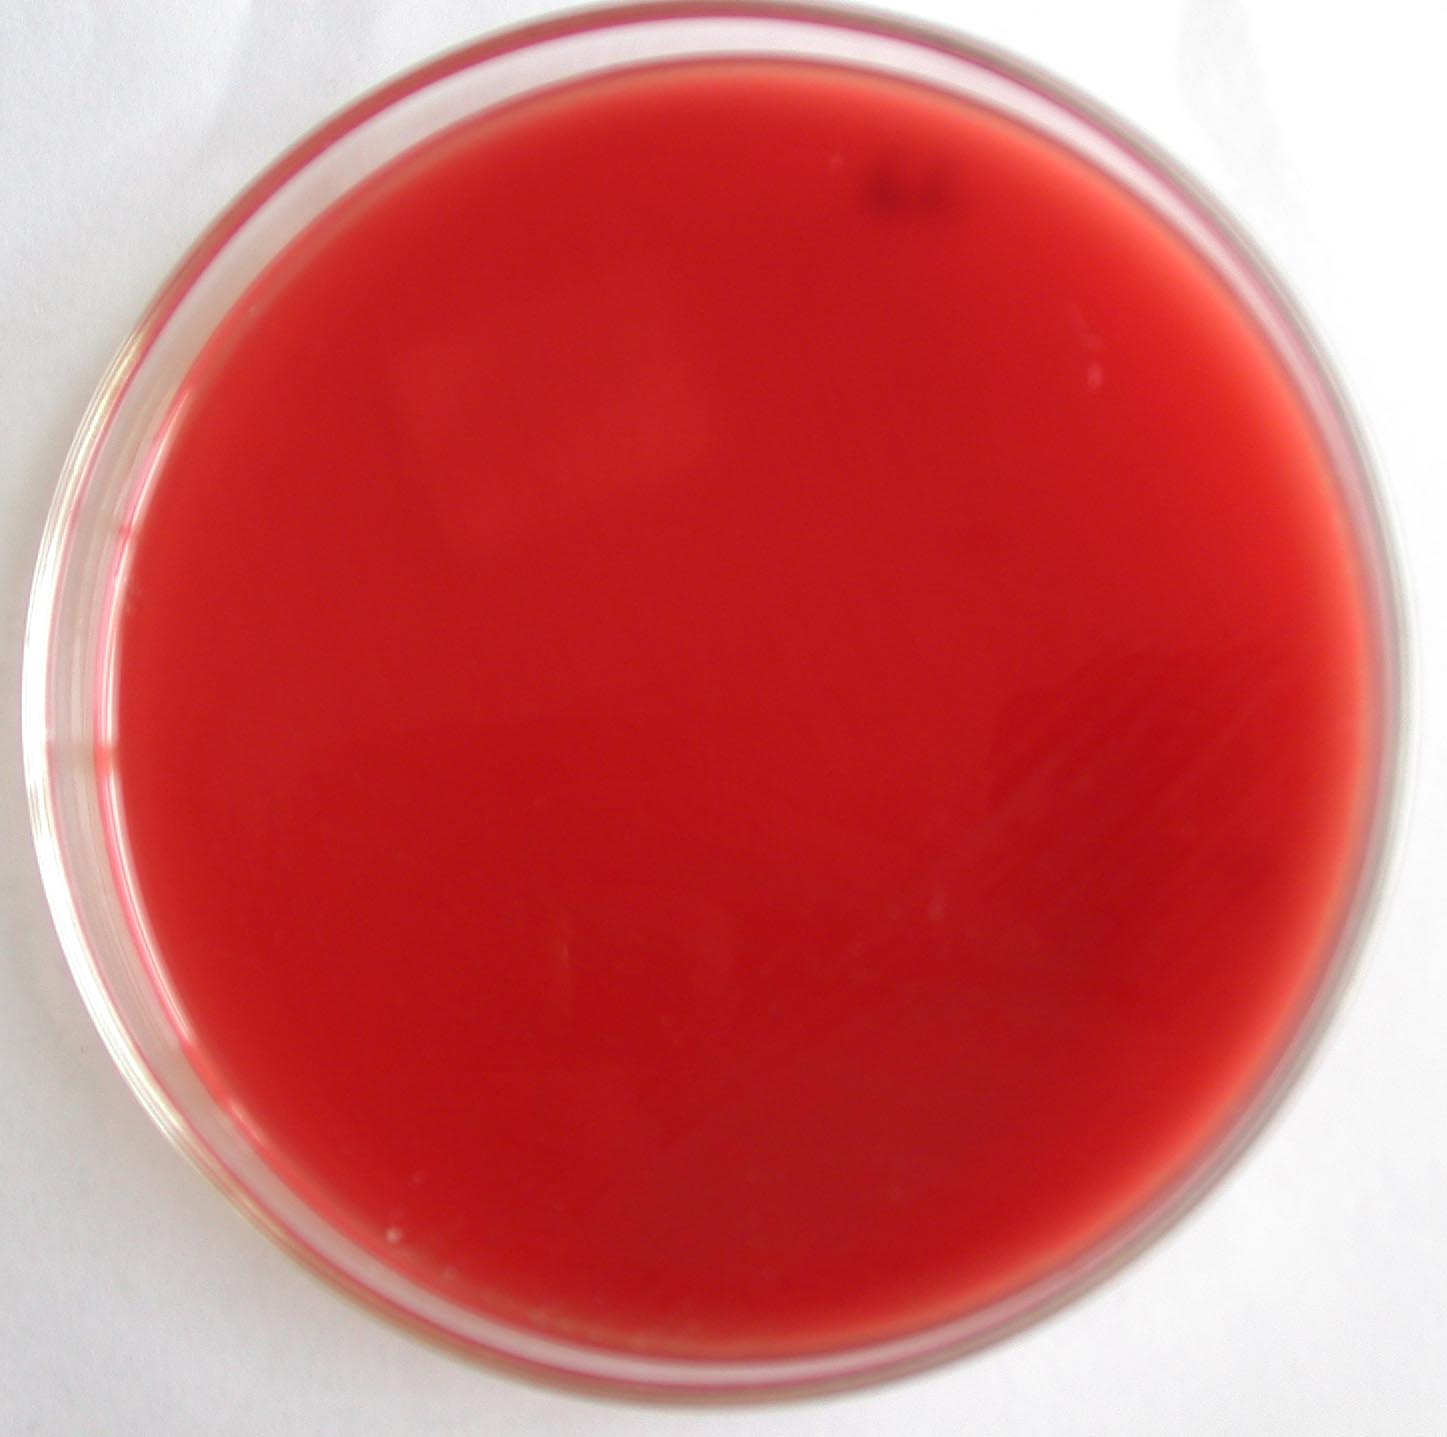
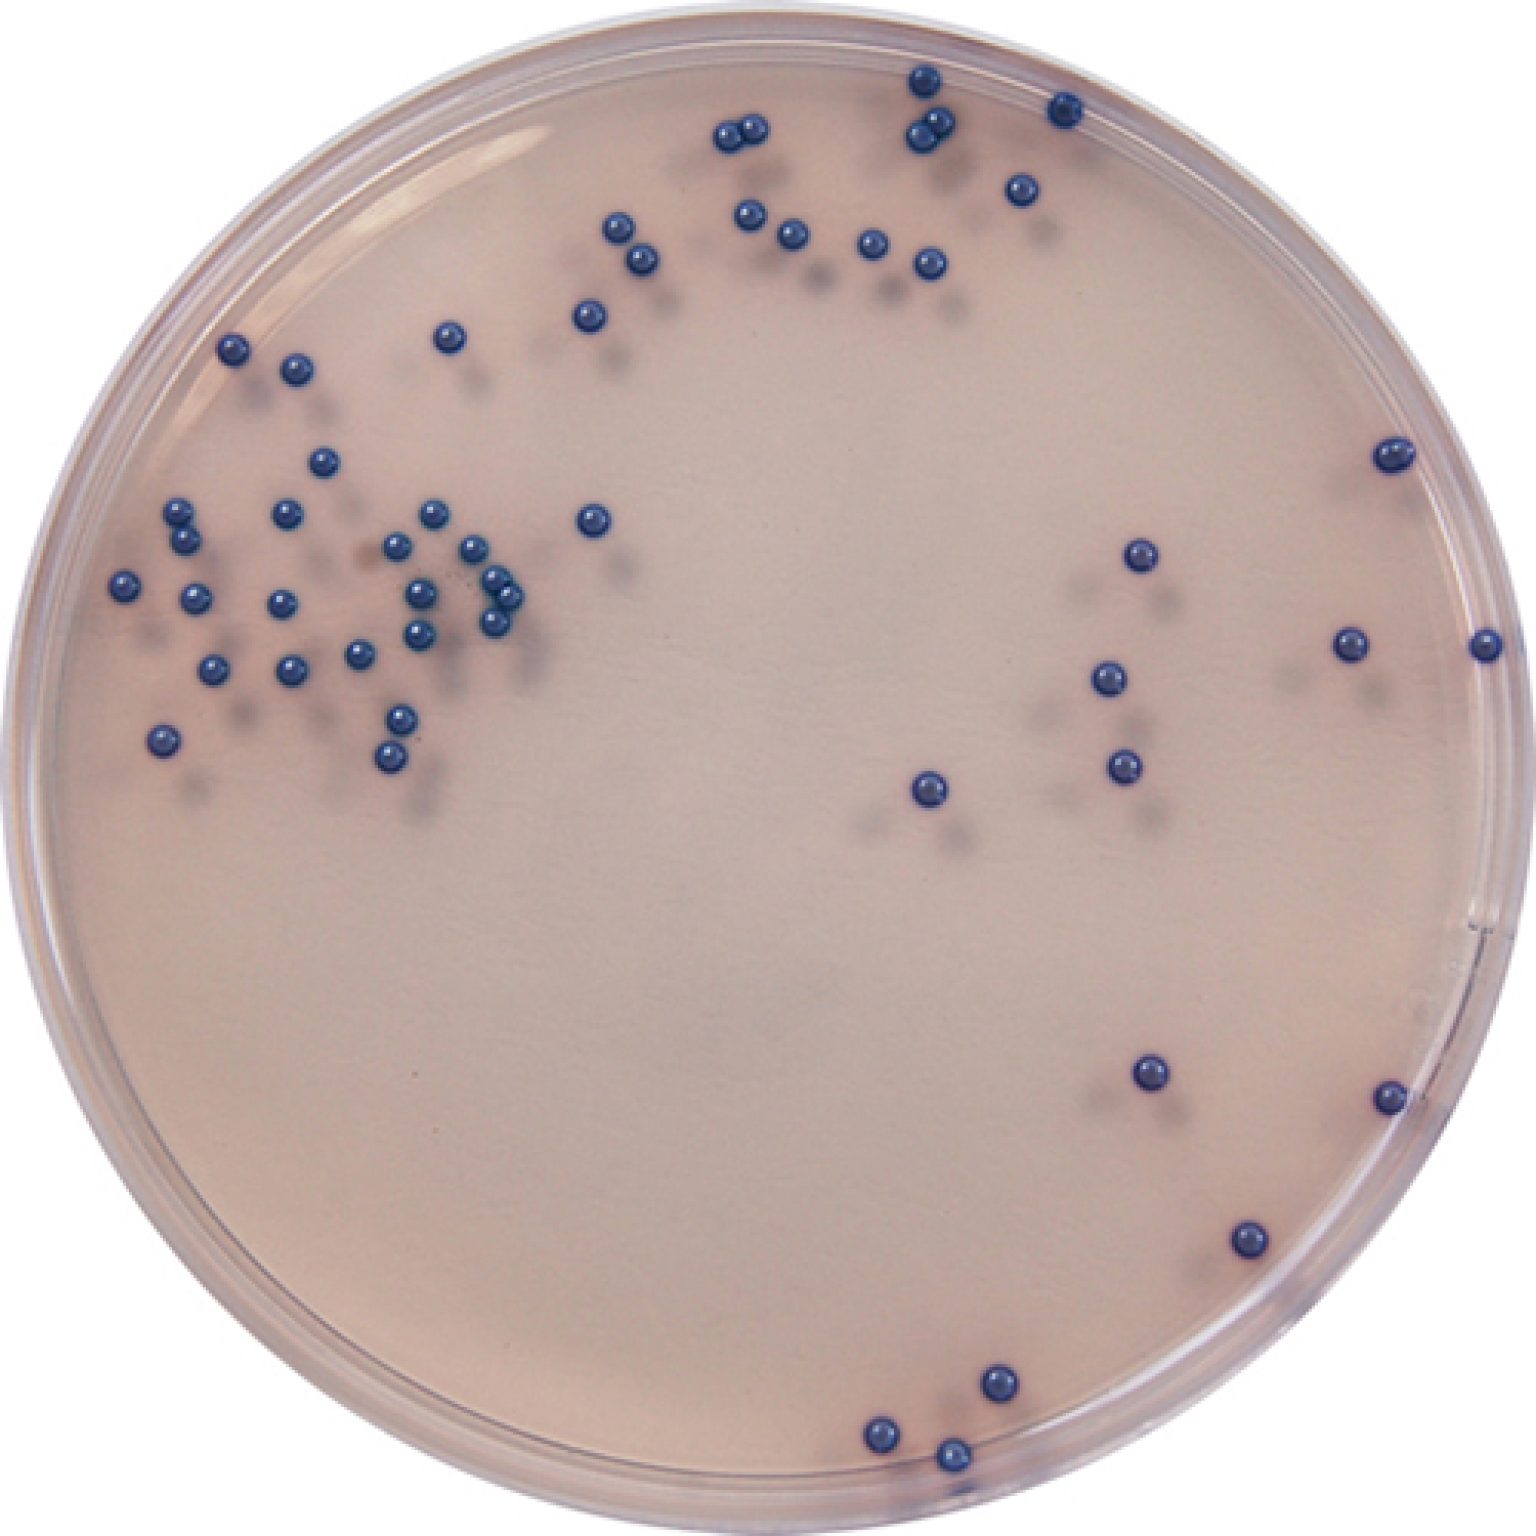

Поверхность агара
Поверхность агара 129 фото
Слушать музыку шансон 2000 х
Врали ударение в слове
Арии из опер слушать марии каллас
Улица ломоносова брянск
Ул арбат 29 вареничная
Радио западной музыки
Выжить любой ценой лакорн с русской
Смотре телевизор
Центр бишкека улицы
Маргулис таня слушать